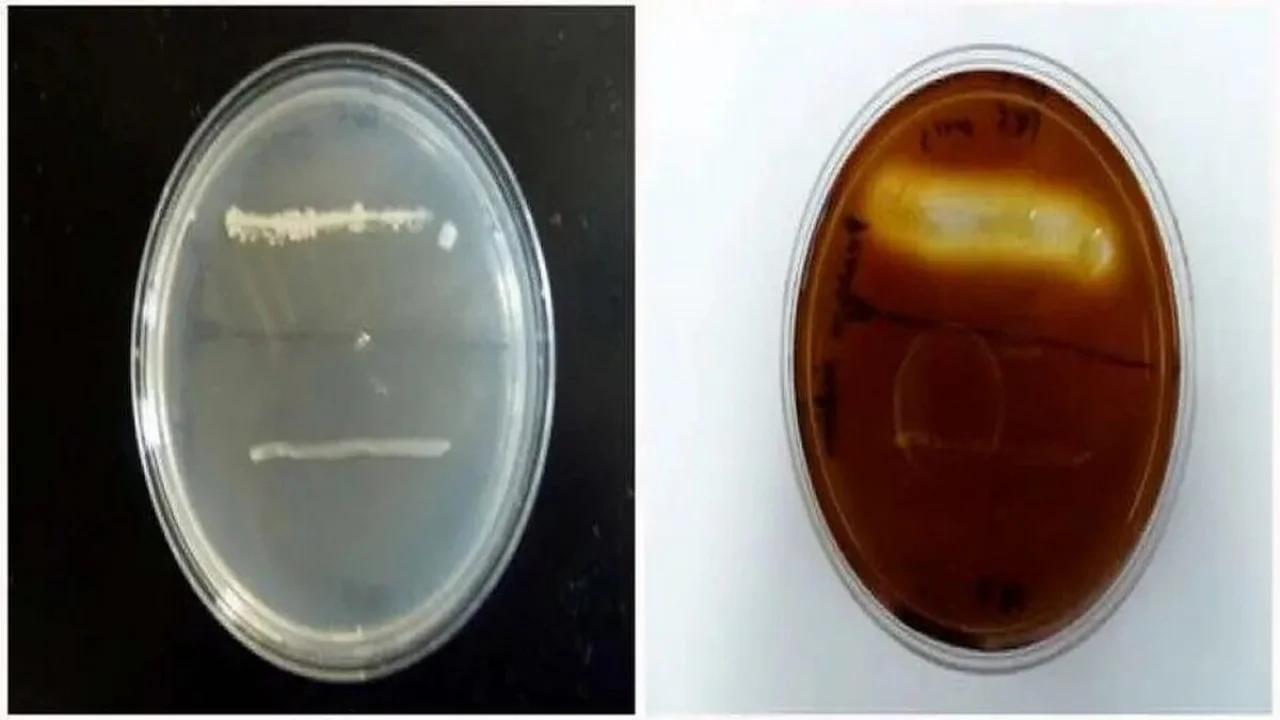

AMYLASE TEST (STARCH HYDROLYSIS)
0
Microbiology
AMYLASE TEST (STARCH HYDROLYSIS)
To determine if the organism is capable of breaking down starch into maltose through the activity of the extra-cellular α-amylase enzyme.
Published:
BS
Login to get unlimited free access
Objective:
To determine if the organism is capable of breaking down starch into maltose through the activity of the extra-cellular α-amylase enzyme.
Test procedure
- Use a sterile swab or a sterile loop to pick a few colonies from your pure culture plate. Streak a starch plate in the form of a line across the width of the plate. Several cultures can be tested on a single agar plate, each represented by a line or the plate may be divided into four quadrants (pie plate) for this purpose.
- Incubate plate at 37 °C for 48 hours.
- Add 2-3 drops of 10% iodine solution directly onto the edge of colonies. Wait 10-15 minutes and record the results.

Interpretation:
-- Positive test ("+"): The medium will turn dark. However, areas surrounding isolated colonies where starch has been hydrolyzed by amylase will appear clear.
-- Negative test ("-"): The medium will be colored dark, right up to the edge of isolated colonies.
Medically Reviewed
The information on this page is peer reviewed by a qualified editorial review board member. Learn more about us and our editorial process.
Last reviewed on .
Article history
- Latest version
Cite this page:
- Comment
- Posted by Dayyal Dungrela
Tags:
Start a Conversation
Add comment
End of the article